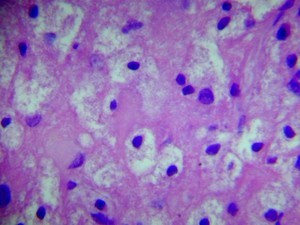

A 95 year old man passes away after experiencing an MI in his sleep. An autopsy of his brain reveals the following changes. His wife states that over the past year he had developed severe memory problems and seemed to have increasing difficulty expressing himself. What is his diagnosis and what types of pathologic changes have occured?

Alzheimer’s disease:
Inheritance:
- Down’s syndrome: increased risk due to Amyloid precursor protein (APP) expression on Chrom 21
- Familial form: 10%:
- Early onset: APP (chrom 21), presenilin-1 (chrom 14), presinilin-2 (chrom 1)
- Late onset: ApoE4 (chrom 19)= protective
Pathophys:
1. Widespread cortical atrophy–> decreased Ach (deficiency of choline acetyltransferase on nucleus basalis of Meynert + hippocampal changes)
- Plaques form first–> Neurofibrillary tangles
- *Amyloid plaques:** (front)
- Extracellular accumulation of A-beta (fragment of the amyloid precursor protein)
- Abnormal processing of APP critical to pathophysiology of Alzheimer’s disease
- *Neurofibrillary tangles: (below)**
- Intracellular, paired helical structures composed of hyperphosphorylated tau.
- Correlate well with disease severity and neuronal death.

Frontotemporal degeneration
Frontotemporal degeneration
Frontotemporal degeneration is a group of neurodegenerative diseases which are distinct from AD and which predominantly involve the frontal lobes of the brain.
The disease was first recognized clinically in 1892 and called Pick’s disease.
The three subtypes are:
- frontotemporal dementia (FTD) or behavioral-variant (bvFTD)
- agrammatic or non-fluent primary progressive aphasia (PPA)
- semantic dementia (SD) or semantic PPA (sPPA)
Clinical:
- Onset typically between 45-65 years of age
- Usually starts in the late 50’s, a younger age than in Alzheimer’s disease.
- *- 60% are hereditary, linked to tau gene on chromosome 17q21-22**
- Often relative sparing of memory
- Characterized by personality change and impaired social conduct.
- Patients may also have emotional blunting and loss of insight.
- Other common features are disinhibition, neglect of personal hygiene, mental rigidity, perseverative behaviors, voracious appetite (especially for sweets) and hypersexuality.
Imaging:
- Focal degeneration of the frontal and temporal lobes, with corresponding cognitive and behavioral disturbances.
Histo:
- Atrophy of frontal and temporal lobes, varyingly severe neuron loss and fibrous gliosis in corpus straitum, substantia nigra and medial thalamus
- Spongy vacuolization primary affecting cortical layer 2
- Pick bodies= spherical tau protein aggregates
Treatment:
- Very limited, treat symptomatically (behavioral changes)
- AchEIs= contraindicated
- No treatments to alter course
A 75 year old man begins to develop tremors and his wife notices that he seems to walk slower around the house. On neurological exam her demonstrates slower movements and writes in smaller handwriting than normal. Based on the gross speciment below, what would his diagnosis be?

Parkinson’s disease:
Four cardinal features:
- Tremor (3-6 Hz rest tremor);
- Bradykinesia;
- Rigidity (cogwheeling);
- Postural instability.
Supportive features:
- Hypomimia and hypophonia,
- micrographia
- stooped-flexed posture
- shuffling gait and festination
- constipation, anosmia, mood and sleep disorders
Pathology:
Loss of pigmented dopaminergic cell in the substantia nigra pars compacta and the formation of Lewy bodies in the brainstem.
- *Lewy bodies (below) are cytoplasmic inclusion bodies that contain alpha-synuclein.**
- Synucleinopathy?
Treatment:
The goal of treatment is to keep the patient functional for as long as possible.
Nonpharmacological treatment such as physical and speech therapy.
Pharmacological treatment aims at replacing or increasing dopamine levels in the brain. Drugs include Carbidopa/Levodopa, dopamine agonists, COMT inhibitors (that increase serum levodopa levels), and MAO-B inhibitors (that inhibit the breakdown of dopamine).
Complications of levodopa therapy include motor fluctuations and dyskinesias.
Deep brain stimulation is an option for select PD patients who have developed motor complications and medically refractory PD.

Huntington’s Disease
CAG trinucleotide repeat disorder (AD):
- Caudate loses Ach and GABA
Chorea, aggression, depression, dementia
Neuronal death- NMDA-R binding, glutamate toxicity
Atrophy of striate nuclei (Caudate)
A 68 year old woman begins having phone conversations with “God”. Additionally she is forgetting where she put various objects her house. Based on her symptomatology and the brain specimen below, what is her diagnosis?

Dementia with Lewy bodies:
Early dementia, hallucinations, cognitive fluctuations
- Alpha-synuclein defect
Creutzfeld-Jacob Disease
Creutzfeld-Jacob disease:
Rapidly progressive dementia with startle myoclonus.
- The duration of illness is typically 4 months and median age at death is 68 years old.
85% of CJD is sporadic.
- Familial CJD associated with various mutations in human prion protein (PrPC, chr 20p) and accounts for only 15% of cases.
- A small number of cases of CJD occur iatrogenically (corneal transplants, neurosurgical EEG electrodes, pooled human growth hormone, dura mater transplants, organ transplants).
New Variant CJD:
Early neuropsychiatric symptoms and ataxia with pyramidal symptoms before dementia.
- The duration of illness is typically 14 months and the median age at death is 28.
- nvCJD is thought to result from the consumption of beef suffering from bovine spongiform encephalopathy (BSE, or ‘mad cow’ disease).
A 55 year old woman with a 10 year history of HIV infection comes to her physician after having trouble moving the left side of her body. She fears she may have had a stroke. Additionally her husband states that her behavior has been strange for the past few months and she has trouble remembering things. A brain biopsy is taken after the MRI fails to reveal an area of ischemia. Based on the histologic sample below (contents of macrophages in neural tissue), what might her diagnosis be?

HIV infection causing neurological changes:
Dementia associated with HIV may be related to actions of cytokines released by macrophages (front) in response to HIV virus infection of these cells.
- HIV in the brain is characterized histologically by the presence of perivascular multinucleated giant cells that have been shown to contain HIV.
Also associated with a vacuolar myelopathy. (below)
- The pathogenesis of the vacuolar myelopathy may also be cytotoxic cytokine release.
- The posterior and lateral columns of the spinal cord show marked vacuolization.
- Clinically patients with vacuolar myelopathy demonstrate ataxia and spastic paraparesis.
- The immunosuppression caused by HIV predisposes the CNS to infection by numerous infectious agents and to the development of CNS B cell lymphomas

A 65 year old homeless man is brought to the emergency room for severe alcohol intoxication. He is given IV fluids and glucose for ressucitation and he appears to improve. On exam the next day however, he has developed some palsy of the lateral rectus muscles and has an inward gaze (esotropia). While interviewing the patient, the physician asks him what year it is, to which the patient replies, “1975”. Out of curiousity, the physician then asks him what color the dog standing next to him is. The patient confidently replies, “that’s a beautiful golden retriever”. Based on the symptoms and gross specimen below, what has happened?

Wernicke’s Encephalopathy:
Petechial hemorrhages present in the mamillary bodies and walls of the third ventricle. (infarction of mamillary bodies)
- Due to thiamine deficiency.
- Thiamine in the form of thiamine pyrophosphate is a cofactor for various enzyme systems such as the pyruvate dehydrogenase complex and transketolase.
- Areas affected in Wernicke’s encephalopathy have highest activity of transketolase.
- Can detect early signs of thiamine deficiency by looking at RBCs: decreased transketolase activity (HMP shunt= only mode of repairing cell membrane damage)–> hemolysis
Symptoms:
- Conjugate gaze and lateral rectus palsies, nystagmus, ataxia and mental confusion are classic features.
A 45 year old woman presents with sudden transient loss of vision in her left eye. On MRI, lesions are found in other sites of her brain and a biopsy is taken that reveals the following. What is her diagnosis and how will she be treated?

Multiple sclerosis:
Primary diagnosis based on dissemination in space:
1. First attack or progression of > 6 months
2. Two or more lesions in appropriate locations:
- periventricular,
- juxtacortical (inferior, posterior fossa)
- cord lesion or asymptomatic infratentorial lesion
Lhermitte’s phenomenon= shock-like sensation radiation to feet with neck flexion
Lesions over time:
1. Presence of asymptomatic enhancing and nonenhancing lesions at any time
2. >= 1 new T2 or enhancing lesion
* Can now diagnose patient at first attack
** risk of having another attack increases based on location of lesions (in diagnostic areas, risk is ~90%)
** Fewer lesions, less likely to have disability at 5 years (10%)
Biomarkers:
- Increased IgG in CSF: oligoclonal bands
Pathogenesis:
Demyelination–> if it stops, axon will re-myelinate
In progression of MS:
Axonal transection and degeneration
- Axon is cut in half before it can regenerate the myelin sheath (See chronic plaque on front)
Treatment:
Reduce likelihood of another attack after precipitating event by administering:
- IFN-beta-1b: reduced risk of new lesion formation
- Natalizumab: Ab against CAM alpha-4 integrin
- S1P receptor antagonists
- Anti-VLA4
- Anti-metabolites
- Anti-neoplastic agents
Acute inflammatory demyelinating radiculopathy
Guillain-Barre Syndrome:
Annual incidence is 1-4 per 100,000 population;
- younger patients;
- can be preceded by URI or GI infection (Campylobacter jejuni, CMV)
- acquired autoimmune neuropathy
Symptoms:
- Ascending weakness of lower and upper limbs < 4 weeks
- Initial distal limb tingling and numbness; may be associated with back or radicular pain
- Subjective sensory disturbance, often without sensory deficit on physical examination and electrodiagnostic test
- Progressive weakness- most frequently distal LE; ascending and symmetric
- Mild paresis to complete paralysis
- Can lead to respiratory compromise requiring intubation
- Generalized hypo or areflexia
Diagnostic testing:
- EMG/ NCS can be normal early on; prolonged F-waves, decreased conduction velocities, CMAP temporal dispersion
- Supportive test: elevated CSF protein with normal cell count (cytoalbuminic dissociation)
- Elevated cell count suggests infection
(Lyme, HIV among others)
- Increased CSF protein with normal cell count–> papilledema
- Autonomic dysfunction: arrhythmias, labile blood pressure, urinary retention; requires CARDIAC MONITORING
Treatment
1. IVIg 2 grams/kg over 2-5 days (more commonly used because of availability); check IgA level before
- Risks: headache, hypotension, rash, aseptic meningitis, thrombosis- stroke, nephrotic syndrome, serum sickness
2. Plasmapheresis 200-250 ml/Kg in 4-6 treatments
- Requires central line
- Risks: hypotension, bleeding and arrhythmias
3. Corticosteroids not beneficial for AIDP
** Clinical response in 2-3 weeks- IVIg/ PE improve neurological deficit and time of recovery (time on ventilator, to walk unaided, % of patients improved 1 and 6 months after onset)
A 45 year old man with a 20-year diagnosis of HIV is brought to the physician by his partner after he notices cognitive changes in his partner. On neurological exam, the physician notes unilateral weakness. An MRI is ordered that reveals the following changes. What is the patient’s probably diagnosis given his presentation and underlying conditions?

Progressive multifocal leukoencephalopathy:
- demyelination secondary to viral destruction of oligodendroglia by JC virus.
JC virus is a polyoma virus that causes a lytic infection of oligodendrocytes in immunocompromised persons.
70-80% of adults worldwide are seropositive for JC virus.
- Patients with compromised immune status especially AIDS patients are at risk for PML.
Histo:
- macrophage infiltration of white matter
- breakdown and phagocytosis of myelin
- loss of oligodendrocytes
- enlarged oligodendrocytes with intranuclear inclusions
- “Bizarre” astrocytes.
Acute disseminated (postinfectious) encephalomyelitis
Multifocal perivenular inflammation, demyelination after infection (measles, VZV) or certain vaccines (rabies, smallpox)
A 10 year old boy is brought to the physician by his mother because she thinks his personality seems to be changing and he is getting clumsier- he has fallen down the stairs twice in the last week. Additionally he doesn’t seem to want to go outside when it is sunny. The pediatrician looks at the boy’s medical records and sees that he suffered from a measles infection at age 2, as his parents refused to have him vaccinated. Based on the changes in the brain tissue specimen below, what is his diagnosis?

Subacute sclerosing panencephalitis:
Encephalitis of insidious onset following measles virus infection
- Occurs in children
- Caused by measles virus defective in terms of M protein (can’t bud) or abnormal immune response
Symptoms: gradual, progressive psychoneurological deterioration, consisting of personality change, seizures, myoclonus, ataxia, photosensitivity, ocular abnormalities, spasticity, and coma.
characterized by astrogliosis of gray and white matter, myelin loss, perivascular lymphocytes and a protracted course
Below: measles virus inclusions within neuron

Metachromatic leukodystrophy
Deficiency of the lysosomal enzyme arylsulfatase A; autosomal recessive
- Impaired production of proteins in myelin sheath
- Late infantile form most common, onset 1-2 years; progressive motor disability, intellectual decline, rapid demise
Path:
- “Metachromatic” deposits of sulfatide in CNS, PNS, and kidney
- Diagnosis made by measurement of enzyme activity, urinary sulfatide excretion; prenatal diagnosis is possible
A 4 month old is brought to the pediatrician for a well visit. His mother states that he has gotten much more irritable over the last month and that after they thought he could sleep through the night he has started waking her up again several times a night. Additionally he has had a couple of fevers that have necessitated going to the Emergency room, where they were unable to find any signs of infection. The pediatrician’s exam reveals developmental delays. Based on the brain biopsy below, what is his diagnosis and prognosis?

Krabbe disease (Globoid Cell Leukodystrophy):
Deficiency of the lysosomal enzyme **beta galactocerebrosidase;
- autosomal recessive**
- Builup of galactocerebroside–> destruction of myelin sheath
Onset and symptoms:
- Late infancy most common (80%), usually before 6 months
- developmental arrest
- extreme irritability and crying followed by rigidity and spasms;
- frequent episodes of pyrexia (fever)
Prognosis: death by 1-2 years with continued seizures and opisthotonus
CNS pathology due to accumulation of psychosine–> loss of oligodendrocytes, myelin
- May also affect the peripheral nervous system
Histo:
- numerous globoid cells, paucity of intact myelin and oligodendrocytes and variable loss of axons.

Charcot-Marie Tooth disease
Most common inherited neurological disorder (1:2,500)
- Hereditary Motor and Sensory Neuropathy (HMSN)
- Distal > proximal weakness, atrophy, and numbness (ex: weak foot dorsiflexion due to common peroneal nerve damage)
- Autosomal dominant common (autosomal recessive and X-linked forms also exist)
Path: defectiv production of proteins in peripheral nerve or myelin sheath
- Most common type CMT1A is caused by duplication or mutation of PMP22, CMT1B mutation of MPZ gene
- Uniform demyelination and slowing on NCS - Axonal variants (CMT2)
- Severe infantile forms (Dejerine-Sottas) CMT3
- CMT4 with childhood onset, multiple genes recognized (PMP22, myelin protein zero, EGR2)
Man with Port-wine stain on face. Gross specimen from brain

Sturge-Weber Syndrome:
Facial port wine stain of the upper face in the distribution of the ophthalmic branch of the trigeminal nerve
- In complete form the cutaneous lesion is accompanied by ipsilateral venous angiomas of the leptomeninges, the choroid of the eye and the choroid plexus
- Usual clinical features include:seizures, motor and sensory deficits, below normal cognitive ability and congenital glaucoma, seizures, mental retardation, hemiparesis; pheochromocytoma
Gross: brain blood vessel abnormalities–> calcification–> brain changes (occured UNDER port wine stain
Histo: vascular changes in brain with calcification


Tuberous Sclerosis:
Autosomal dominant disorder
1: 10,000-100,000
- Characteristic CNS lesions are multiple firm hamartomatous masses involving the cortex
- SEGAs (subependymal giant cell astrocytomas) = coat ependyma
Features:
- Hamartomas in CNS, skin
- Adenoma sebaceum (cutaneous angiofibromas)
- Mitral regurgitation
- Ash-leaf spots
- Cardiac rhabdomyoma
- Mental retardation
- renal Angiomyolipoma
- Seizures


Neurofibromatosis Type 1:
- Autosomal dominant, affecting 1:3000-1:4000 persons
- High new mutation rate.
- Tumors involving the CNS include optic gliomas, astrocytomas and rarely ependymomas.
- Malignant peripheral nerve sheath tumors arise from neurofibromas in approximately 5% of affected patients.
Front: Neurofibromas along spinal cord


Schwanomas of NFT2:
Autosomal dominant
Occurs in 1:135,000 persons
Gene located on chromosome 22
Bilateral “acoustic neuromas” (schwannomas).
Other common tumors include meningiomas and low grade gliomas.
Schwannoma= nuclear palisading
- Found at cerebellopontine angle
- S-100 positive (same as melanomas= neural crest cell derived)
- Spindle cells with oval nuclei
Antoni A= high cellular pattern–> pallisading picket fence
Antoni B= myxoid, low cellular pattern


Von HIppel-Lindau Syndrome:
Autosomal dominant disorder (VHL gene on Chrom 3= tumor suppressor gene- may play role in exit from cell cycle)
Prevalence of approximately 1:40.OOO.
Tumors include:
- “retinal angioma” (hemangioblastoma),
- hemangioblastomas of brain and spinal cord
- renal cell carcinoma
- pheochromocytomas.
Below: renal cell carcinoma


Glioblastoma multiforme:
High grade astrocytic tumor cellular pleomorphism, mitotic activity, necrosis and vascular proliferation
- Diagnositic staining: stain astrocytes for GFAP
- Can cross corpus callosum–> positional headaches (Butterfly glioma on MRI)
Front: pseduopalisading necrosis
Genome-wide analysis of gliomas= somatic mutations of Isocitrate Dehydrogenase 1 (12%)- 5/6 of secondary gliobastomas
Below: vascular proliferation driven by VEGF= diagnostic feature in glioblastoma
- Treated with avastin (Bevacizumab)


Meningioma:
Relatively common neoplasms accounting for approximately 15% of all primary intracranial tumors. Occur in middle life, usually after the third decade. Tumors originate from arachnoidal cap cells
* Arises from meninges–> pushes INTO brain
Histo: meningioma whorls


Oligodendroglioma:
Frontal lobes, Chicken-wire capillary pattern
“Fried egg cells”= round nuclei with clear cytoplasm, calcified in oligodendroglioma
Most encountered in adulthood.
Infiltrating gliomas that most often occur in adults and typically involve the cerebral hemispheres
Often slow clinical evolution with long history of seizures,
the result of their tendency to infiltrate cortical grey matter
** Patients with 1p19q deletion fare better, respond better to chemotherapy
* Can become malignant: 6 mitoses/HPF–> worse survival














